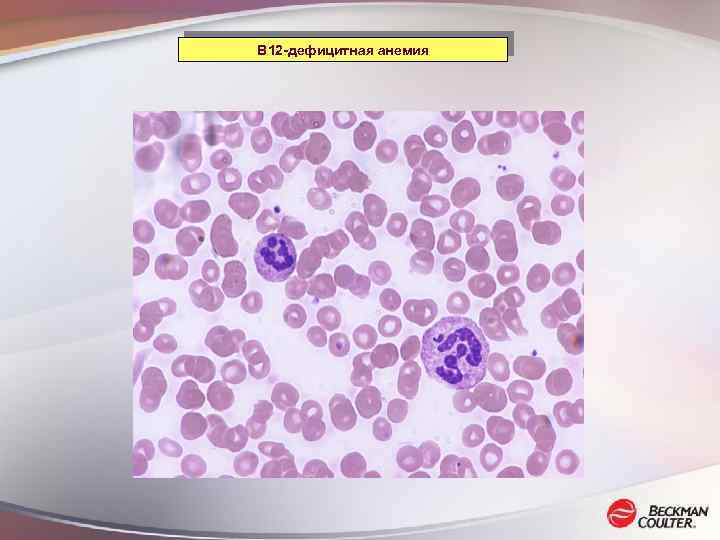

ANEMIA_INT.ppt
- Количество слайдов: 76

 ЖЕЛЕЗО В ОРГАНИЗМЕ ЧЕЛОВЕКА ДРУГОЕ (6%) Хранение (27%) (Ферритин) Fe(III) Fe(II) Функционально активный Транспортный пул Пул (Гемоглобин+Миоглобин) (Трансферрин) (<1%) (67%)
ЖЕЛЕЗО В ОРГАНИЗМЕ ЧЕЛОВЕКА ДРУГОЕ (6%) Хранение (27%) (Ферритин) Fe(III) Fe(II) Функционально активный Транспортный пул Пул (Гемоглобин+Миоглобин) (Трансферрин) (<1%) (67%)
 ЖЕЛЕЗО В организме взрослого человека массой 70 кг содержится 3, 5 – 4, 5 г железа, основная часть которого связана с белками РАСПРЕДЕЛЕНИЕ ЖЕЛЕЗА В ОРГАНИЗМЕ ЧЕЛОВЕКА Соединения Концентрация, мг на 1 кг массы тела мужчины женщины Гемоглобин 31 28 Миоглобин 4. 0 3. 5 Ферменты 1. 5 1. 0 Трансферрин 0. 5 Ферритин 13 5
ЖЕЛЕЗО В организме взрослого человека массой 70 кг содержится 3, 5 – 4, 5 г железа, основная часть которого связана с белками РАСПРЕДЕЛЕНИЕ ЖЕЛЕЗА В ОРГАНИЗМЕ ЧЕЛОВЕКА Соединения Концентрация, мг на 1 кг массы тела мужчины женщины Гемоглобин 31 28 Миоглобин 4. 0 3. 5 Ферменты 1. 5 1. 0 Трансферрин 0. 5 Ферритин 13 5
 МЕТАБОЛИЗМ ЖЕЛЕЗА Система моноцитов-макрофагов Циркулирующие красные кровяные клетки Мышцы, другие паренхимальные клетки Фер. ТФ Кишечный тракт Фер. Гепатоциты Эритроидные клетки - Функциональный пул - Транспортный пул - Хранение
МЕТАБОЛИЗМ ЖЕЛЕЗА Система моноцитов-макрофагов Циркулирующие красные кровяные клетки Мышцы, другие паренхимальные клетки Фер. ТФ Кишечный тракт Фер. Гепатоциты Эритроидные клетки - Функциональный пул - Транспортный пул - Хранение
 ЖЕЛЕЗОДЕФИЦИТНАЯ АНЕМИЯ КРИТЕРИИ И ХАРАКТЕРИСТИКИ • цветовой показатель < 0, 85 • среднее содержание гемоглобина в эритроците (MCH) < 24 пг • средняя концентрация гемоглобина в эритроците (MCHC) < 30 г/дл • микроцитоз – средний объем эритроцита (MCV) < 75 мкм 3 • Сывороточное железо < 12 мкмоль/л
ЖЕЛЕЗОДЕФИЦИТНАЯ АНЕМИЯ КРИТЕРИИ И ХАРАКТЕРИСТИКИ • цветовой показатель < 0, 85 • среднее содержание гемоглобина в эритроците (MCH) < 24 пг • средняя концентрация гемоглобина в эритроците (MCHC) < 30 г/дл • микроцитоз – средний объем эритроцита (MCV) < 75 мкм 3 • Сывороточное железо < 12 мкмоль/л
 ПАНЕЛЬ БИОХИМИЧЕСКИХ ТЕСТОВ ДЛЯ ОЦЕНКИ МЕТАБОЛИЗМА ЖЕЛЕЗА – Сывороточное железо – Общая железосвязывающая способность сыворотки (ОЖСС) – Ненасыщенная железосвязывающая способность сыворотки – Ферритин – Трансферрин – Насыщение трасферрина – Растворимый рецептор трансферрина – Гаптоглобин – Электрофорез форм гемоглобина
ПАНЕЛЬ БИОХИМИЧЕСКИХ ТЕСТОВ ДЛЯ ОЦЕНКИ МЕТАБОЛИЗМА ЖЕЛЕЗА – Сывороточное железо – Общая железосвязывающая способность сыворотки (ОЖСС) – Ненасыщенная железосвязывающая способность сыворотки – Ферритин – Трансферрин – Насыщение трасферрина – Растворимый рецептор трансферрина – Гаптоглобин – Электрофорез форм гемоглобина
 ЖЕЛЕЗО В СЫВОРОТКЕ ДИАГНОСТИЧЕСКАЯ ЗНАЧИМОСТЬ • Железо ↑ при гемолитической, апластической анемии, болезни Аддисона-Бирмера • Железо ↓ при железодефицитной анемии ОГРАНИЧЕНИЯ • Концентрация железа подвержена суточным колебаниям (циркадные ритмы) • Возрастные и половые различия в уровне железа сыворотки крови • Ненадежность большинства методов определения концентрации железа
ЖЕЛЕЗО В СЫВОРОТКЕ ДИАГНОСТИЧЕСКАЯ ЗНАЧИМОСТЬ • Железо ↑ при гемолитической, апластической анемии, болезни Аддисона-Бирмера • Железо ↓ при железодефицитной анемии ОГРАНИЧЕНИЯ • Концентрация железа подвержена суточным колебаниям (циркадные ритмы) • Возрастные и половые различия в уровне железа сыворотки крови • Ненадежность большинства методов определения концентрации железа
 Концентрация железа (мкмоль/л) в сыворотке крови здоровых доноров при ежедневном определении (CVi = 26. 6, CVg = 23. 3) [Арефьева, 2006]
Концентрация железа (мкмоль/л) в сыворотке крови здоровых доноров при ежедневном определении (CVi = 26. 6, CVg = 23. 3) [Арефьева, 2006]
![СРАВНЕНИЕ ВНУТРИИНДИВИДУАЛЬНОЙ ВАРИАЦИИ КРЕАТИНИНА И ЖЕЛЕЗА [Арефьева, 2006] СРАВНЕНИЕ ВНУТРИИНДИВИДУАЛЬНОЙ ВАРИАЦИИ КРЕАТИНИНА И ЖЕЛЕЗА [Арефьева, 2006]](https://present5.com/presentation/-57943447_218245235/image-9.jpg) СРАВНЕНИЕ ВНУТРИИНДИВИДУАЛЬНОЙ ВАРИАЦИИ КРЕАТИНИНА И ЖЕЛЕЗА [Арефьева, 2006]
СРАВНЕНИЕ ВНУТРИИНДИВИДУАЛЬНОЙ ВАРИАЦИИ КРЕАТИНИНА И ЖЕЛЕЗА [Арефьева, 2006]
 ФЕРРИТИН СТРУКТУРА • Состоит из белковой оболочки, апоферритина (молекулярная масса 445 к. Да) • Апоферритин состоит из 24 субъединиц двух типов (Н и L) • Ферритин, циркулирующий в крови, состоит главным образом из L субъединиц • Апоферритин содержит до 4500 атомов железа в ядре ФУНКЦИЯ • Форма депонирования железа в организме • Железо, связанное с ферритином используется для синтеза гема (при интенсивном синтезе гемоглобина) • Включение железа в ферритин требует предварительного окисления Fe 2+ в Fe 3+
ФЕРРИТИН СТРУКТУРА • Состоит из белковой оболочки, апоферритина (молекулярная масса 445 к. Да) • Апоферритин состоит из 24 субъединиц двух типов (Н и L) • Ферритин, циркулирующий в крови, состоит главным образом из L субъединиц • Апоферритин содержит до 4500 атомов железа в ядре ФУНКЦИЯ • Форма депонирования железа в организме • Железо, связанное с ферритином используется для синтеза гема (при интенсивном синтезе гемоглобина) • Включение железа в ферритин требует предварительного окисления Fe 2+ в Fe 3+
 ФЕРРИТИН ЛОКАЛИЗАЦИЯ • Ферритин накапливается в печени, селезенке, мышцах и костном мозге ЗНАЧИМОСТЬ ДЛЯ ДИАГНОСТИКИ • Наиболее специфичный и чувствительный параметр при наличии запасов железа в организме • Норма 15 -200 нг/мл (мкг/л)
ФЕРРИТИН ЛОКАЛИЗАЦИЯ • Ферритин накапливается в печени, селезенке, мышцах и костном мозге ЗНАЧИМОСТЬ ДЛЯ ДИАГНОСТИКИ • Наиболее специфичный и чувствительный параметр при наличии запасов железа в организме • Норма 15 -200 нг/мл (мкг/л)
 ФЕРРИТИН – ОГРАНИЧЕНИЯ при ДИАГНОСТИКЕ • Низкая информативность при беременности • Большой разброс референсных значений • Концентрация ферритина возрастает при - заболеваниях печени - т. н. «парадоксальное повышение ферритина» наблюдается при неопластических процессах (опухолях) - при анемии хронических заболеваний (почки) - воспалении (необходимо параллельно измерять уровень С-реактивного белка)
ФЕРРИТИН – ОГРАНИЧЕНИЯ при ДИАГНОСТИКЕ • Низкая информативность при беременности • Большой разброс референсных значений • Концентрация ферритина возрастает при - заболеваниях печени - т. н. «парадоксальное повышение ферритина» наблюдается при неопластических процессах (опухолях) - при анемии хронических заболеваний (почки) - воспалении (необходимо параллельно измерять уровень С-реактивного белка)
 ОЦЕНКА ЗАПАСОВ ЖЕЛЕЗА В ОРГАНИЗМЕ ПО УРОВНЮ ФЕРРИТИНА (по данным ВОЗ) ЗАПАСЫ ЖЕЛЕЗА СЫВОРОТОЧНЫЙ ФЕРРИТИН (нг/мл) МУЖЧИНЫ ЖЕНЩИНЫ ЗАПАСЫ ЖЕЛЕЗА ИСТОЩЕНЫ < 15 ЗАПАСЫ ЖЕЛЕЗА ИСТОЩЕНЫ+ИНФЕКЦИЯ < 30 РИСК ПЕРЕГРУЗКИ ЖЕЛЕЗОМ > 200 > 150
ОЦЕНКА ЗАПАСОВ ЖЕЛЕЗА В ОРГАНИЗМЕ ПО УРОВНЮ ФЕРРИТИНА (по данным ВОЗ) ЗАПАСЫ ЖЕЛЕЗА СЫВОРОТОЧНЫЙ ФЕРРИТИН (нг/мл) МУЖЧИНЫ ЖЕНЩИНЫ ЗАПАСЫ ЖЕЛЕЗА ИСТОЩЕНЫ < 15 ЗАПАСЫ ЖЕЛЕЗА ИСТОЩЕНЫ+ИНФЕКЦИЯ < 30 РИСК ПЕРЕГРУЗКИ ЖЕЛЕЗОМ > 200 > 150
 ТРАНСФЕРРИН (TФ) СТРУКТУРА и ЛОКАЛИЗАЦИЯ • Гликопротеин • Молекулярный вес – 89 к. Да (по другим данным 76 -77 к. Да) • Каждая молекула ТФ связывает 2 атома железа Fe 3+ • Синтезируется в печени ФУНКЦИЯ • Главный плазменный белок – переносчик железа • Основной донор железа для продукции гемоглобина • 1 мг ТФ связывает 1, 25 мкг железа • В физиологических условиях ТФ насыщен железом примерно на 30% • После высвобождения железа из комплекса с ТФ ион Fe 3+ должен быть восстановлен в Fe 2+
ТРАНСФЕРРИН (TФ) СТРУКТУРА и ЛОКАЛИЗАЦИЯ • Гликопротеин • Молекулярный вес – 89 к. Да (по другим данным 76 -77 к. Да) • Каждая молекула ТФ связывает 2 атома железа Fe 3+ • Синтезируется в печени ФУНКЦИЯ • Главный плазменный белок – переносчик железа • Основной донор железа для продукции гемоглобина • 1 мг ТФ связывает 1, 25 мкг железа • В физиологических условиях ТФ насыщен железом примерно на 30% • После высвобождения железа из комплекса с ТФ ион Fe 3+ должен быть восстановлен в Fe 2+
 ТРАНСФЕРРИН (TФ) ОГРАНИЧЕНИЯ • Концентрация ТФ подвержена суточным колебаниям • Острое воспаление способствует понижению уровня ТФ КЛИНИЧЕСКАЯ ЗНАЧИМОСТЬ Основной клинический показатель для дифференцировки между железодефицитной (ТФ↑) и гемолитической анемией (ТФ↓) Более точный показатель, чем ОЖСС
ТРАНСФЕРРИН (TФ) ОГРАНИЧЕНИЯ • Концентрация ТФ подвержена суточным колебаниям • Острое воспаление способствует понижению уровня ТФ КЛИНИЧЕСКАЯ ЗНАЧИМОСТЬ Основной клинический показатель для дифференцировки между железодефицитной (ТФ↑) и гемолитической анемией (ТФ↓) Более точный показатель, чем ОЖСС
 ЦИКЛ ТРАНСФЕРРИНА ВНЕКЛЕТОЧНОЕ ПРОСТРАНСТВО ТФ(Fe 3+)2 apo. ТФ р. Н 7. 4 Рецепторы ТФ Растворимый рецептор ТФ Протеолиз Рецепторы ТФ КЛАТРИНОВЫЙ ПУЗЫРЕК ЦИТОПЛАЗМА р. Н < 5. 5 [Cox et al. , 1990] р. Н 5. 5 ЭНДОСОМА СВОБОДНОЕ ЖЕЛЕЗО
ЦИКЛ ТРАНСФЕРРИНА ВНЕКЛЕТОЧНОЕ ПРОСТРАНСТВО ТФ(Fe 3+)2 apo. ТФ р. Н 7. 4 Рецепторы ТФ Растворимый рецептор ТФ Протеолиз Рецепторы ТФ КЛАТРИНОВЫЙ ПУЗЫРЕК ЦИТОПЛАЗМА р. Н < 5. 5 [Cox et al. , 1990] р. Н 5. 5 ЭНДОСОМА СВОБОДНОЕ ЖЕЛЕЗО
 РЕЦЕПТОР ТРАСФЕРРИНА И РАСТВОРИМЫЙ РЕЦЕПТОР ТРАНСФЕРРИНА Рецептор ТФ Трансмембранный белок с молекулярной массой 95 к. Да 80% рецепторов ТФ находится на эритроидных клетках Растворимый рецептор ТФ – укороченная форма рецептора ТФ Стабильный полипептид длиной 100 АК
РЕЦЕПТОР ТРАСФЕРРИНА И РАСТВОРИМЫЙ РЕЦЕПТОР ТРАНСФЕРРИНА Рецептор ТФ Трансмембранный белок с молекулярной массой 95 к. Да 80% рецепторов ТФ находится на эритроидных клетках Растворимый рецептор ТФ – укороченная форма рецептора ТФ Стабильный полипептид длиной 100 АК
 РАСТВОРИМЫЙ РЕЦЕПТОР ТРАНСФЕРРИНА: БИОЛОГИЧЕСКАЯ АКТИВНОСТЬ - Количество рецепторов ТФ на поверхности клеток зависит от концентрации железа в цитоплазме, т. е. от потребностей клетки в железе. - Количество растворимого рецептора ТФ в сыворотке пропорционально количеству рецептора ТФ на поверхности клеток и отражает количество эритроидных клеток (уровень эритропоэза) При недостатке железа количество растворимого рецептора ТФ в сыворотке возрастает
РАСТВОРИМЫЙ РЕЦЕПТОР ТРАНСФЕРРИНА: БИОЛОГИЧЕСКАЯ АКТИВНОСТЬ - Количество рецепторов ТФ на поверхности клеток зависит от концентрации железа в цитоплазме, т. е. от потребностей клетки в железе. - Количество растворимого рецептора ТФ в сыворотке пропорционально количеству рецептора ТФ на поверхности клеток и отражает количество эритроидных клеток (уровень эритропоэза) При недостатке железа количество растворимого рецептора ТФ в сыворотке возрастает
 РАСТВОРИМЫЙ РЕЦЕПТОР ТРАНСФЕРРИНА: КЛИНИЧЕСКАЯ ЗНАЧИМОСТЬ • Оценка эритропоэза при хронических заболеваниях почек, апластической анемии, после химиотерапии • Контроль за эритропоэзом после пересадки костного мозга • Оценка эффективности терапии рекомбинантным эритропоэтином при анемии, связанной с нарушением работы почек
РАСТВОРИМЫЙ РЕЦЕПТОР ТРАНСФЕРРИНА: КЛИНИЧЕСКАЯ ЗНАЧИМОСТЬ • Оценка эритропоэза при хронических заболеваниях почек, апластической анемии, после химиотерапии • Контроль за эритропоэзом после пересадки костного мозга • Оценка эффективности терапии рекомбинантным эритропоэтином при анемии, связанной с нарушением работы почек
 КЛИНИЧЕСКАЯ ЗНАЧИМОСТЬ ФЕРРИТИНА И РАСТВОРИМОГО РЕЦЕПТОРА ТРАНСФЕРРИНА ФЕРРИТИН РАСТВОРИМЫЙ РЕЦЕПТОР ТФ 1000 20 мг/л 10 300 7 7 100 6 6 50 50 5 5 4 4 2500 нг/мл 1000 15 15 5 5 1 1 ЖДА+ А. хр. с. А. хр. с. [Punnonen et al. , Blood, 1997] 3 2. 5 2 1. 5 1 0 3 2. 5 2 1. 5 1 0 ЖДА+ А. хр. с.
КЛИНИЧЕСКАЯ ЗНАЧИМОСТЬ ФЕРРИТИНА И РАСТВОРИМОГО РЕЦЕПТОРА ТРАНСФЕРРИНА ФЕРРИТИН РАСТВОРИМЫЙ РЕЦЕПТОР ТФ 1000 20 мг/л 10 300 7 7 100 6 6 50 50 5 5 4 4 2500 нг/мл 1000 15 15 5 5 1 1 ЖДА+ А. хр. с. А. хр. с. [Punnonen et al. , Blood, 1997] 3 2. 5 2 1. 5 1 0 3 2. 5 2 1. 5 1 0 ЖДА+ А. хр. с.
 ДИФФЕРЕНЦИАЛЬНЫЙ ДИАГНОЗ: ЖЕЛЕЗОДЕФИЦИТНАЯ АНЕМИЯ И АНЕМИЯ ХРОНИЧЕСКИХ СОСТОЯНИЙ Железодефицитная анемия хр. состояний Измерить ферритин Ферритин<15 нг/мл Да Нет Ферритин>220 нг/мл Да Железодефицитная Да Нежелезодефицитная анемия хр. состояний [North, Clin Lab Haemotol, 1997] Нет Растворимый Рецептор ТФ выше нормы Нет Нежелезодефицитная анемия хр. состояний
ДИФФЕРЕНЦИАЛЬНЫЙ ДИАГНОЗ: ЖЕЛЕЗОДЕФИЦИТНАЯ АНЕМИЯ И АНЕМИЯ ХРОНИЧЕСКИХ СОСТОЯНИЙ Железодефицитная анемия хр. состояний Измерить ферритин Ферритин<15 нг/мл Да Нет Ферритин>220 нг/мл Да Железодефицитная Да Нежелезодефицитная анемия хр. состояний [North, Clin Lab Haemotol, 1997] Нет Растворимый Рецептор ТФ выше нормы Нет Нежелезодефицитная анемия хр. состояний
 РАСТВОРИМЫЙ РЕЦЕПТОР ТРАНСФЕРРИНА: ОГРАНИЧЕНИЯ • Отсутствие референсных значений для беременных и детей • Повышенный уровень растворимого рецептора ТФ при: – Нарушении эритропоэза (талассемия, мегалобластная анемия, сидеробластная анемия) – Повышенном уровне эффективного эритропоэза (гемолитическая анемия, потеря крови и др. ) – Серповидно-клеточной анемии
РАСТВОРИМЫЙ РЕЦЕПТОР ТРАНСФЕРРИНА: ОГРАНИЧЕНИЯ • Отсутствие референсных значений для беременных и детей • Повышенный уровень растворимого рецептора ТФ при: – Нарушении эритропоэза (талассемия, мегалобластная анемия, сидеробластная анемия) – Повышенном уровне эффективного эритропоэза (гемолитическая анемия, потеря крови и др. ) – Серповидно-клеточной анемии
 ЗНАЧЕНИЕ ЛАБОРАТОРНЫХ ТЕСТОВ ДЛЯ РАННЕЙ ДИАГНОСТИКИ АНЕМИИ Нормальный статус Истощение запасов железа (стадия I) Запасы железа Истощение функциональноактивного пула железа (стадия II) (стадия III) Железодефицит- Железодефицитный эритропоэз ная анемия Транспортный пул Функционально-активный пул Гемоглобин Растворимый Рецептор ТФ Ферритин 15 -203 нг/мл < 22 нг/мл < 15 нг/мл Р. рец. ТФ 1. 15 -2. 75 мг/л < 2. 75 мг/л > 3. 6 мг/л Hb муж. Hb жен. 128 -168 г/л 117 -153 г/л > 128 г/л > 117 г/л < 128 г/л < 117 г/л [Suominen et al. , Blood, 1998]
ЗНАЧЕНИЕ ЛАБОРАТОРНЫХ ТЕСТОВ ДЛЯ РАННЕЙ ДИАГНОСТИКИ АНЕМИИ Нормальный статус Истощение запасов железа (стадия I) Запасы железа Истощение функциональноактивного пула железа (стадия II) (стадия III) Железодефицит- Железодефицитный эритропоэз ная анемия Транспортный пул Функционально-активный пул Гемоглобин Растворимый Рецептор ТФ Ферритин 15 -203 нг/мл < 22 нг/мл < 15 нг/мл Р. рец. ТФ 1. 15 -2. 75 мг/л < 2. 75 мг/л > 3. 6 мг/л Hb муж. Hb жен. 128 -168 г/л 117 -153 г/л > 128 г/л > 117 г/л < 128 г/л < 117 г/л [Suominen et al. , Blood, 1998]
 ДИАГНОСТИКА ГИПОХРОМНЫХ АНЕМИЙ Гипохромная анемия (цв. показатель < 0. 85; MCH ниже нормы) Сывороточное железо понижено Да Нет Железонасыщенная а. + Гемолитическая а. Железодефицитная а. + А. хр. состояний Ферритин понижен, ТФ или ОЖСС повышены, р. р. ТФ повышен Да Ретикулоциты повышены Нет Железодефицитная а. А. хр. состояний Да Нет Железонасыщенная а. (Ферритин в норме/повышен) Гемолитическая а. (ТФ понижен)
ДИАГНОСТИКА ГИПОХРОМНЫХ АНЕМИЙ Гипохромная анемия (цв. показатель < 0. 85; MCH ниже нормы) Сывороточное железо понижено Да Нет Железонасыщенная а. + Гемолитическая а. Железодефицитная а. + А. хр. состояний Ферритин понижен, ТФ или ОЖСС повышены, р. р. ТФ повышен Да Ретикулоциты повышены Нет Железодефицитная а. А. хр. состояний Да Нет Железонасыщенная а. (Ферритин в норме/повышен) Гемолитическая а. (ТФ понижен)
 Распространенность анемии в мире Данные ВОЗ
Распространенность анемии в мире Данные ВОЗ
 Этиология анемии у пожилых пациентов Около 100 различных причин анемии
Этиология анемии у пожилых пациентов Около 100 различных причин анемии
 Анемия: Симптомы • • Выраженность симптомов зависит от тяжести анемии Часто симптомы анемии игнорируются или приписываются наличию других заболеваний Центральная нервная система • Утомляемость • Депрессия • Ослабление умственных способностей Пищеварительная система • Анорексия • Тошнота Сосудистая система • Пониженная температура кожи • Бледность кожных покровов Иммунная система Ослабление функций Т-клеток и макрофагов Сердечно-сосудистая система • Одышка при физической нагрузке • Тахикардия, сердцебиение • Гипертрофия сердечной мышцы • Повышенное давление, систолический шум • Риск сердечных расстройств Половая система • Расстройства менструального цикла • Потеря либидо Adapted from Ludwig H, et al, Semin Oncol 2001; 28(suppl 8): 7 -14
Анемия: Симптомы • • Выраженность симптомов зависит от тяжести анемии Часто симптомы анемии игнорируются или приписываются наличию других заболеваний Центральная нервная система • Утомляемость • Депрессия • Ослабление умственных способностей Пищеварительная система • Анорексия • Тошнота Сосудистая система • Пониженная температура кожи • Бледность кожных покровов Иммунная система Ослабление функций Т-клеток и макрофагов Сердечно-сосудистая система • Одышка при физической нагрузке • Тахикардия, сердцебиение • Гипертрофия сердечной мышцы • Повышенное давление, систолический шум • Риск сердечных расстройств Половая система • Расстройства менструального цикла • Потеря либидо Adapted from Ludwig H, et al, Semin Oncol 2001; 28(suppl 8): 7 -14
 Анемия: Ключевые моменты • Анемия – распространенное явление, особенно у детей, беременных женщин и пожилых людей • Анемия ухудшает качество жизни и связана с увеличением риска смертности и повышением заболеваемости. • Анемия не диагностируется должным образом • Лечение анемии может существенно улучшить положение пациентов
Анемия: Ключевые моменты • Анемия – распространенное явление, особенно у детей, беременных женщин и пожилых людей • Анемия ухудшает качество жизни и связана с увеличением риска смертности и повышением заболеваемости. • Анемия не диагностируется должным образом • Лечение анемии может существенно улучшить положение пациентов
 Диагностика анемии • Стандартный анализ крови ( CBC) – Количество эритроцитов, RBC – 106/µL – Количество лейкоцитов, WBC – Количество тромбоцитов, Plt – Гемоглобин – g/d. L – Гематокрит - % • Дополнительные тесты – Количество ретикулоцитов - % от количества RBC – Характеристика эритроцитов • Средний объем эритроцита (MCV) - f. L • Среднее содержание гемоглобина в эритроците (MCH) - pg • Средняя концентрация гемоглобина в эритроците (MCHC) – g/d. L • Ширина распределения эритроцитов (RDW) LH 750
Диагностика анемии • Стандартный анализ крови ( CBC) – Количество эритроцитов, RBC – 106/µL – Количество лейкоцитов, WBC – Количество тромбоцитов, Plt – Гемоглобин – g/d. L – Гематокрит - % • Дополнительные тесты – Количество ретикулоцитов - % от количества RBC – Характеристика эритроцитов • Средний объем эритроцита (MCV) - f. L • Среднее содержание гемоглобина в эритроците (MCH) - pg • Средняя концентрация гемоглобина в эритроците (MCHC) – g/d. L • Ширина распределения эритроцитов (RDW) LH 750
 Ручной подсчет ретикулоцитов - Значительные затраты времени - Невысокая точность результатов - Окраска с помощью красителя brilliant cresyl blue - На результат анализа влияют качество окрашивания, субъективность в оценке результатов
Ручной подсчет ретикулоцитов - Значительные затраты времени - Невысокая точность результатов - Окраска с помощью красителя brilliant cresyl blue - На результат анализа влияют качество окрашивания, субъективность в оценке результатов
 Автоматический подсчет ретикулоцитов Флуоресцентное окрашивание РНК с использованием акридиновых красителей (Thiazol Orange или Coriphosphine O) и анализ результатов с помощью Проточной Цитометрии Анализируемые Прямое и боковое рассеяние ретикулоцитов cвойства: и интенсивность флуоресценции РНК Параметры : Количество ретикулоцитов, индекс зрелости (MI) Суправитальное окрашивание РНК эндоплазматического ретикулума с использованием красителя New Methylen Blue и анализ с помощью Гематологического Анализатора Анализируемые Импеданс (объем), проводимость и рассеяние Свойства: лазерного света ретикулоцитами Параметры: Количество ретикулоцитов, индекс зрелости (MI), МRV, MSCV, HLR, морфометрические данные
Автоматический подсчет ретикулоцитов Флуоресцентное окрашивание РНК с использованием акридиновых красителей (Thiazol Orange или Coriphosphine O) и анализ результатов с помощью Проточной Цитометрии Анализируемые Прямое и боковое рассеяние ретикулоцитов cвойства: и интенсивность флуоресценции РНК Параметры : Количество ретикулоцитов, индекс зрелости (MI) Суправитальное окрашивание РНК эндоплазматического ретикулума с использованием красителя New Methylen Blue и анализ с помощью Гематологического Анализатора Анализируемые Импеданс (объем), проводимость и рассеяние Свойства: лазерного света ретикулоцитами Параметры: Количество ретикулоцитов, индекс зрелости (MI), МRV, MSCV, HLR, морфометрические данные
 Сравнение результатов ручного и автоматического методов подсчета ретикулоцитов % % N=60 N=50 % Ретикулоциты на анализаторе % Gen*S vs EPICS XL (Цитометрия) y = 1, 013 x+0, 422 r = 0, 977 % Ретикулоциты на анализаторе Gen*S vs Ручная микроскопия y = 0, 81 x+0, 07 r = 0, 988 Lahary A et al. Feuillets de Biologie, 1998: (225) 55 -58
Сравнение результатов ручного и автоматического методов подсчета ретикулоцитов % % N=60 N=50 % Ретикулоциты на анализаторе % Gen*S vs EPICS XL (Цитометрия) y = 1, 013 x+0, 422 r = 0, 977 % Ретикулоциты на анализаторе Gen*S vs Ручная микроскопия y = 0, 81 x+0, 07 r = 0, 988 Lahary A et al. Feuillets de Biologie, 1998: (225) 55 -58
 Анализ ретикулоцитов с помощью метода Культера 1. Этап: Суправитальное окрашивание с помощью New Methylen Blue для детекции и преципитации РНК в эндоплазматическом ретикулуме 2. Этап: Добавление специального реагента для придания эритроцитам сферической формы и удаления гемоглобина; Эритроциты становятся оптически нейтральными 3. Этап: Анализ 32. 000 эритроцитов и представление данных в виде трехмерного куба в осях объем, проводимость, рассеяние (VCS); аналог трехмерной диаграммы лейкоцитов при дифференцировке
Анализ ретикулоцитов с помощью метода Культера 1. Этап: Суправитальное окрашивание с помощью New Methylen Blue для детекции и преципитации РНК в эндоплазматическом ретикулуме 2. Этап: Добавление специального реагента для придания эритроцитам сферической формы и удаления гемоглобина; Эритроциты становятся оптически нейтральными 3. Этап: Анализ 32. 000 эритроцитов и представление данных в виде трехмерного куба в осях объем, проводимость, рассеяние (VCS); аналог трехмерной диаграммы лейкоцитов при дифференцировке
 Технология VCS V – Volume C-Conductivity S -Scatter
Технология VCS V – Volume C-Conductivity S -Scatter
 VCS технология
VCS технология
 LH 750 - анализ результатов: Возможность вращения трехмерной диаграммы
LH 750 - анализ результатов: Возможность вращения трехмерной диаграммы
 Анализ ретикулоцитов с помощью метода Культера О Б Ъ Е М Ретикулоциты Эритроциты РАССЕЯНИЕ ПРОВОДИМОСТЬ
Анализ ретикулоцитов с помощью метода Культера О Б Ъ Е М Ретикулоциты Эритроциты РАССЕЯНИЕ ПРОВОДИМОСТЬ
 Диаграмма анализа ретикулоцитов
Диаграмма анализа ретикулоцитов
 Анализ ретикулоцитов на гематологическом анализаторе LH 750 IRF
Анализ ретикулоцитов на гематологическом анализаторе LH 750 IRF
 Индекс зрелости ретикулоцитов Фракция незрелых ретикулоцитов (IRF) 1 RBC 2 3 4 5 Ретикулоциты Зрелые Незрелые Фракции 3 -10 IRF = Все Рет (0 -10) 6 7 8 9 10
Индекс зрелости ретикулоцитов Фракция незрелых ретикулоцитов (IRF) 1 RBC 2 3 4 5 Ретикулоциты Зрелые Незрелые Фракции 3 -10 IRF = Все Рет (0 -10) 6 7 8 9 10
 Индекс незрелости ретикулоцитов и общее количество ретикулоцитов HLR % = IRF x RETI % HLR # = IRF x RETI #
Индекс незрелости ретикулоцитов и общее количество ретикулоцитов HLR % = IRF x RETI % HLR # = IRF x RETI #
 Параметры для ретикулоцитов – количество и индексы зрелости
Параметры для ретикулоцитов – количество и индексы зрелости
 Ретикулоциты и индексы зрелости Нормальные значения
Ретикулоциты и индексы зрелости Нормальные значения
 Анализ ретикулоцитов – маркеры, коды и диагностические сообщения
Анализ ретикулоцитов – маркеры, коды и диагностические сообщения
 Клинические применения параметров для ретикулоцитов АНАЛИЗ РЕТИКУЛОЦИТОВ ГЕМАТОЛОГИЯ ·Диагностика анемий ·Мониторинг гематологических пациентов ØМониторинг пациентов при пересадке костного мозга. ØМониторинг последствий аплазии. ХИРУРГИЯ/ ТЕРАПИЯ ·Анализ действия токсическоих препаратов на костный мозг. ·Обнаружение скрытых геморрагий или компенсированного гемолиза. ·Контроль эриторопоэтической активности после кровотечения. НЕФРОЛОГИЯ ·Контроль лечения эритропоэтином ·Контроль приживаемости почечных трансплантантов ·Ранний диагноз дефицитных состояний у пациентов с почечной недостаточностью ПЕДИАТРИЯ/ АКУШЕРСТВО ·Выявление риска случаев синдрома внезапной смерти новорожденных. ·Мониторинг фетоматеринской изоиммунизации
Клинические применения параметров для ретикулоцитов АНАЛИЗ РЕТИКУЛОЦИТОВ ГЕМАТОЛОГИЯ ·Диагностика анемий ·Мониторинг гематологических пациентов ØМониторинг пациентов при пересадке костного мозга. ØМониторинг последствий аплазии. ХИРУРГИЯ/ ТЕРАПИЯ ·Анализ действия токсическоих препаратов на костный мозг. ·Обнаружение скрытых геморрагий или компенсированного гемолиза. ·Контроль эриторопоэтической активности после кровотечения. НЕФРОЛОГИЯ ·Контроль лечения эритропоэтином ·Контроль приживаемости почечных трансплантантов ·Ранний диагноз дефицитных состояний у пациентов с почечной недостаточностью ПЕДИАТРИЯ/ АКУШЕРСТВО ·Выявление риска случаев синдрома внезапной смерти новорожденных. ·Мониторинг фетоматеринской изоиммунизации
 Клинические применения параметров для ретикулоцитов (продолжение) IRF – аналог «левого сдвига» для нейтрофилов В норме – не более 5% от общего количества ретикулоцитов Высвобождаются при интенсивной стимуляции эритропоэза (при геморрагиях, анемиях, при терапии, стимулирующей продукцию костного мозга) • Мониторинг клеточной регенерации после пересадки костного мозга • Мониторинг регенерации костного мозга после химиотерапии • Мониторинг терапии с помощью железа, фолата или В 12 • Мониторинг влияния токсических лекарств на костный мозг • Мониторинг приживаемости почечных трансплантантов посредством анализа эритропоэза • Классфикация анемий • Мониторинг показаний к неонатальной трансфузии • Выявление апластических кризов • Выявление неонатальной гипоксии
Клинические применения параметров для ретикулоцитов (продолжение) IRF – аналог «левого сдвига» для нейтрофилов В норме – не более 5% от общего количества ретикулоцитов Высвобождаются при интенсивной стимуляции эритропоэза (при геморрагиях, анемиях, при терапии, стимулирующей продукцию костного мозга) • Мониторинг клеточной регенерации после пересадки костного мозга • Мониторинг регенерации костного мозга после химиотерапии • Мониторинг терапии с помощью железа, фолата или В 12 • Мониторинг влияния токсических лекарств на костный мозг • Мониторинг приживаемости почечных трансплантантов посредством анализа эритропоэза • Классфикация анемий • Мониторинг показаний к неонатальной трансфузии • Выявление апластических кризов • Выявление неонатальной гипоксии
 Классификация анемий По этиологии и патогенезу: По насыщению эритроцитов гемоглобином • Гипохромные (ЦП< 0, 8) • Нормохромные (ЦП 0, 9 -1, 0) • Гиперхромные (ЦП = 1, 0) • Постгеморрагические анемии острая и хроническая • Анемии вследствие нарушения кровообразования По диаметру эритроцитов (MCV) (железодефицитные, рефрактерные, фолиево- • Микроцитарные (MCV<7, 2 мкм) • Нормоцитарные (7, 16
Классификация анемий По этиологии и патогенезу: По насыщению эритроцитов гемоглобином • Гипохромные (ЦП< 0, 8) • Нормохромные (ЦП 0, 9 -1, 0) • Гиперхромные (ЦП = 1, 0) • Постгеморрагические анемии острая и хроническая • Анемии вследствие нарушения кровообразования По диаметру эритроцитов (MCV) (железодефицитные, рефрактерные, фолиево- • Микроцитарные (MCV<7, 2 мкм) • Нормоцитарные (7, 16
 Дифференциальный диагноз анемии 1. Параметр: Гемоглобин Нормальные значения: Женщины 12, 3 - 15, 3 g/dl Мужчины 14, 0 - 17, 5 g/dl Cord Blood 1. день 14. - 23. день 40. - 50. день 5 -7 мес 1, 5 - 3 лет 10 лет 15 лет Анемия: 13, 5 - 20, 7 g/dl 15, 2 - 23, 5 g/dl 12, 7 - 18, 7 g/dl 9, 0 - 16, 6 g/dl 10, 1 - 12, 9 g/dl 10, 8 - 12, 8 g/dl 11, 9 - 15, 0 g/dl 12, 8 - 16, 8 g/dl Женщины < 12 g/dl Мужчины < 13 g/dl Беременные < 11 g/dl Дети (6 M. - 6 Y. ) < 11 /g/dl Дети (6 - 14 Y. ) <12 g/dl
Дифференциальный диагноз анемии 1. Параметр: Гемоглобин Нормальные значения: Женщины 12, 3 - 15, 3 g/dl Мужчины 14, 0 - 17, 5 g/dl Cord Blood 1. день 14. - 23. день 40. - 50. день 5 -7 мес 1, 5 - 3 лет 10 лет 15 лет Анемия: 13, 5 - 20, 7 g/dl 15, 2 - 23, 5 g/dl 12, 7 - 18, 7 g/dl 9, 0 - 16, 6 g/dl 10, 1 - 12, 9 g/dl 10, 8 - 12, 8 g/dl 11, 9 - 15, 0 g/dl 12, 8 - 16, 8 g/dl Женщины < 12 g/dl Мужчины < 13 g/dl Беременные < 11 g/dl Дети (6 M. - 6 Y. ) < 11 /g/dl Дети (6 - 14 Y. ) <12 g/dl
 Гемоглобин и гематокрит изменяются параллельно Гемоглобин: Женщины 12, 3 - 15, 3 g/dl Мужчины 14, 0 - 17, 5 g/dl Гематокрит: Женщины > 36 % (>0, 36) Мужчины > 40 % (>0, 40)
Гемоглобин и гематокрит изменяются параллельно Гемоглобин: Женщины 12, 3 - 15, 3 g/dl Мужчины 14, 0 - 17, 5 g/dl Гематокрит: Женщины > 36 % (>0, 36) Мужчины > 40 % (>0, 40)
 Дифференциальный диагноз анемий 2. Параметр: MCV (средний объем эритроцита) Микроцитарныегипохромные Нормоцитарныенормохромные Железодефицитная анемия Анемия вследствие острой кровопотери Анемия хронических заболеваний Гемолитическая анемия ß-талассемия Анемия вследствие почечной недостаточности Миелодиспластический синдром с кольцевидными сидеробластами Инфильтрация костного мозга у пациентов с МДС, лейкемией, миелофиброзом, миеломами, метастазами Макроцитарныегиперхромные B 12 -дефицитная анемия Фолиево-дефицитная анемия Заболевания печени Гипотиреоз, Хронические обструктивные легочные заболевания, МДС
Дифференциальный диагноз анемий 2. Параметр: MCV (средний объем эритроцита) Микроцитарныегипохромные Нормоцитарныенормохромные Железодефицитная анемия Анемия вследствие острой кровопотери Анемия хронических заболеваний Гемолитическая анемия ß-талассемия Анемия вследствие почечной недостаточности Миелодиспластический синдром с кольцевидными сидеробластами Инфильтрация костного мозга у пациентов с МДС, лейкемией, миелофиброзом, миеломами, метастазами Макроцитарныегиперхромные B 12 -дефицитная анемия Фолиево-дефицитная анемия Заболевания печени Гипотиреоз, Хронические обструктивные легочные заболевания, МДС
 Дифференциальный диагноз анемий: микроцитарные-гипохромные 3. Параметр: Ферритин Вопрос: В каком состоянии запасы железа в организме? Ферритин: низкий Ферритин: нормальный/высокий ß-талассемия Железодефицитная анемия Миелодиспластический синдром с кольцевиднымисидеробластами Анемия хронических заболеваний
Дифференциальный диагноз анемий: микроцитарные-гипохромные 3. Параметр: Ферритин Вопрос: В каком состоянии запасы железа в организме? Ферритин: низкий Ферритин: нормальный/высокий ß-талассемия Железодефицитная анемия Миелодиспластический синдром с кольцевиднымисидеробластами Анемия хронических заболеваний
 Железодефицитная анемия
Железодефицитная анемия
 Дифференциальный диагноз анемий: микроцитарные-гипохромные Классические и новые параметры Дефицит железа Хрон. восп. ß-Thalassemia MCV MRV MSCV MCV-MSCV --n n n -- ---- Reti IRF HLR % MRV/MCV -/n n + + ++ n + Retics MC-V MC-C MC-S -n n - -+
Дифференциальный диагноз анемий: микроцитарные-гипохромные Классические и новые параметры Дефицит железа Хрон. восп. ß-Thalassemia MCV MRV MSCV MCV-MSCV --n n n -- ---- Reti IRF HLR % MRV/MCV -/n n + + ++ n + Retics MC-V MC-C MC-S -n n - -+
 Дифференциальный диагноз анемий : Нормоцитарные-нормохромные 3. Параметр: Ретикулоциты Вопрос: Нарушение образования эритроцитов или кровопотеря? Ретикулоциты: низкие/нормальные Анемия вследствие почечной недостаточности Инфильтрация костного мозга у пациентов с МДС, лейкемией, миелофиброзом, миеломами, метастазами Ретикулоциты: повышены Анемия вследствие острой кровопотери Гемолитическая анемия
Дифференциальный диагноз анемий : Нормоцитарные-нормохромные 3. Параметр: Ретикулоциты Вопрос: Нарушение образования эритроцитов или кровопотеря? Ретикулоциты: низкие/нормальные Анемия вследствие почечной недостаточности Инфильтрация костного мозга у пациентов с МДС, лейкемией, миелофиброзом, миеломами, метастазами Ретикулоциты: повышены Анемия вследствие острой кровопотери Гемолитическая анемия
 Гемолитическая анемия Spherocytes Polychr. RBC LY NE
Гемолитическая анемия Spherocytes Polychr. RBC LY NE
 Дифференциальный диагноз анемий : Нормоцитарные-нормохромные Классические и новые параметры Остр. кровопотеря Гемолиз Почечн. анемия MCV MRV MSCV MCV-MSCV n n n n n Reti IRF HLR % MRV/MCV + n n + ++ n n --- Retics MC-V MC-C MC-S n n n + -- -+
Дифференциальный диагноз анемий : Нормоцитарные-нормохромные Классические и новые параметры Остр. кровопотеря Гемолиз Почечн. анемия MCV MRV MSCV MCV-MSCV n n n n n Reti IRF HLR % MRV/MCV + n n + ++ n n --- Retics MC-V MC-C MC-S n n n + -- -+
 Дифференциальный диагноз анемий: Макроцитарные-гиперхромные 3. Параметр: Форма RBC Вопрос: специфический или неспецифический дефицит субстрата? Не мегалобластная Мегалобластная Заболевания печени В 12 –дефицитная анемия Гипотиреоз, Хронические обструктивные легочные заболевания, МДС Фолиево-дефицитная анемия
Дифференциальный диагноз анемий: Макроцитарные-гиперхромные 3. Параметр: Форма RBC Вопрос: специфический или неспецифический дефицит субстрата? Не мегалобластная Мегалобластная Заболевания печени В 12 –дефицитная анемия Гипотиреоз, Хронические обструктивные легочные заболевания, МДС Фолиево-дефицитная анемия
 В 12 -дефицитная анемия normal Vit. B 12 Deficiency
В 12 -дефицитная анемия normal Vit. B 12 Deficiency
В 12 -дефицитная анемия
В 12 -дефицитная анемия
 Дифференциальный диагноз анемий: Макроцитарные-гиперхромные Классические и новые параметры B 12/Folic Acid Liver Dis. MDS MCV MRV MSCV MCV-MSCV + n + -- + + + - n/+ -n/++ Reti IRF HLR % MRV/MCV -/n n n n ---- Retics MC-V MC-C MC-S n + n - -n
Дифференциальный диагноз анемий: Макроцитарные-гиперхромные Классические и новые параметры B 12/Folic Acid Liver Dis. MDS MCV MRV MSCV MCV-MSCV + n + -- + + + - n/+ -n/++ Reti IRF HLR % MRV/MCV -/n n n n ---- Retics MC-V MC-C MC-S n + n - -n
 Ретикулоциты и индексы зрелости Тип патологии Возможная причина анемии Ret IRF Трансплантация костного мозга Трансплантация, сопровождаемая курсами химиотерапии или облучения Гемолитическая анемия Понижено Повышено Повышен Дефицит железа Нормальное или пониженное Нормальное или повышенное Нормальное или пониженное Понижено Повышен Хронический гемолиз Недостаточный синтез гемоглобина Нарушение синтеза ДНК Мегалобластная анемия вследствие дефицита витамина B 12 или фолата Недавние геморрагии Травма; хирургическое вмешательство, внутренняя геморрагия Талассемия Нарушение в синтезе цепей глобина Повышен Недостаточность эритропоэза Миелодиспластический синдром Недостаточность костного мозга Анемия, вызванная недостаточностью продукции Недостаточность костного мозга Инфильтрация костного мозга Костномозговая аплазия Понижено Нормальный или повышенный Понижен Миелоидная или лимфоидная лейкемия, лимфомы Понижено Понижен
Ретикулоциты и индексы зрелости Тип патологии Возможная причина анемии Ret IRF Трансплантация костного мозга Трансплантация, сопровождаемая курсами химиотерапии или облучения Гемолитическая анемия Понижено Повышено Повышен Дефицит железа Нормальное или пониженное Нормальное или повышенное Нормальное или пониженное Понижено Повышен Хронический гемолиз Недостаточный синтез гемоглобина Нарушение синтеза ДНК Мегалобластная анемия вследствие дефицита витамина B 12 или фолата Недавние геморрагии Травма; хирургическое вмешательство, внутренняя геморрагия Талассемия Нарушение в синтезе цепей глобина Повышен Недостаточность эритропоэза Миелодиспластический синдром Недостаточность костного мозга Анемия, вызванная недостаточностью продукции Недостаточность костного мозга Инфильтрация костного мозга Костномозговая аплазия Понижено Нормальный или повышенный Понижен Миелоидная или лимфоидная лейкемия, лимфомы Понижено Понижен
 Ретикулоциты и индексы зрелости
Ретикулоциты и индексы зрелости
 Ретикулоциты и индексы зрелости Гемолитические анемии Count RET% RET#109/L IRF HLR% HLR # 109/L Норма (Доноры) 66 0. 6 -2. 4 28 -129 0. 20 -0. 48 0. 16 -1. 15 7 -54 Малярия (без анемии) 16 0. 8 -2. 9 36 -117 0. 18 -0. 43 0. 19 -1. 25 10 -59 Малярия(с анемией) 17 1. 3 -10. 6 50 -241 0. 30 -0. 61 0. 40 -5. 80 13 -131 Аутоиммунный 7 2. 5 -32. 1 74 -662 0. 35 -0. 64 1. 1 -20. 4 31 -421 гемолиз Гомозиготная 41 3. 5 -22. 2 100 -592 0. 25 -0. 68 1. 3 -14. 4 40 -571 серповидноклеточная анемия Другие патологии 9 3. 4 -13. 5 127 -508 0. 24 -0. 53 0. 8 -5. 8 28 -203 гемоглобина Group 1: Гемолитические анемии: 74 пациента (41 -гомозиготная серповидноклеточная анемия, 9 -другие аномалии гемоглобина, 17 - малярия с анемией, 7 -аутоиммунный гемолиз. Group 2: негемолитические пациенты : 174 пациента (66 -норма, 16 -малярия без анемии, 33 -лимфоидная лейкемия, Coombs’ test негативный, 27 -острая лейкемия, 6 - B 12 -дефицитная анемия, 21 - пациенты, получающие химиотерапию, 5 -первичная полицитемия). Критерий Count RET# > 100 IRF > 0, 4 HLR%> 1 HLR #> 35 Чувствительность (%) 74 90. 5 74. 3 93. 3 Специфичность (%) 174 93. 1 76. 4 91. 3 93. 1 Эффективность (%) 248 92. 3 75. 8 91. 9 93. 2 Fourcade C, Jary L. Coulter GEN. S et indices réticulocytaires dans les hémolyses : observations préliminaires/ Reticulocytes parameters in some hemolysis syndromes: preliminary results obtained with the Coulter GEN. S. Annales de Biologie Clinique, 1999.
Ретикулоциты и индексы зрелости Гемолитические анемии Count RET% RET#109/L IRF HLR% HLR # 109/L Норма (Доноры) 66 0. 6 -2. 4 28 -129 0. 20 -0. 48 0. 16 -1. 15 7 -54 Малярия (без анемии) 16 0. 8 -2. 9 36 -117 0. 18 -0. 43 0. 19 -1. 25 10 -59 Малярия(с анемией) 17 1. 3 -10. 6 50 -241 0. 30 -0. 61 0. 40 -5. 80 13 -131 Аутоиммунный 7 2. 5 -32. 1 74 -662 0. 35 -0. 64 1. 1 -20. 4 31 -421 гемолиз Гомозиготная 41 3. 5 -22. 2 100 -592 0. 25 -0. 68 1. 3 -14. 4 40 -571 серповидноклеточная анемия Другие патологии 9 3. 4 -13. 5 127 -508 0. 24 -0. 53 0. 8 -5. 8 28 -203 гемоглобина Group 1: Гемолитические анемии: 74 пациента (41 -гомозиготная серповидноклеточная анемия, 9 -другие аномалии гемоглобина, 17 - малярия с анемией, 7 -аутоиммунный гемолиз. Group 2: негемолитические пациенты : 174 пациента (66 -норма, 16 -малярия без анемии, 33 -лимфоидная лейкемия, Coombs’ test негативный, 27 -острая лейкемия, 6 - B 12 -дефицитная анемия, 21 - пациенты, получающие химиотерапию, 5 -первичная полицитемия). Критерий Count RET# > 100 IRF > 0, 4 HLR%> 1 HLR #> 35 Чувствительность (%) 74 90. 5 74. 3 93. 3 Специфичность (%) 174 93. 1 76. 4 91. 3 93. 1 Эффективность (%) 248 92. 3 75. 8 91. 9 93. 2 Fourcade C, Jary L. Coulter GEN. S et indices réticulocytaires dans les hémolyses : observations préliminaires/ Reticulocytes parameters in some hemolysis syndromes: preliminary results obtained with the Coulter GEN. S. Annales de Biologie Clinique, 1999.
 Диагностическая схема при анемии Анемии Hb < 13 g/dl Hb < 12 g/dl Нормоцитарная/макроциартная Микроцитарная анемия MCV > 80 fl MCV < 80 fl Ret < 80 000/mm 3 Ret > 100 000/mm 3 IRF & HLR норма/повышен (1) IRF & HLR норма/понижен Периферическая регенеративная Центральная арегенеративная Ret. > 100 000/mm 3 Ret. < 80 000/mm 3 (1) HLR% >1 IRF > 0. 4 IRF < 0. 4 (2) Гемолиз Талассемия (1)According to Watanabe (2)According to results obtained by Fourcade and Jary (3)According to study by Chiron et al. (4)According to unpublished results HLR% < 1 IRF >0. 4 Сидеропеническая анемия/ Анемия воспаления HLR% = 1 (4) Серповидноклеточная анемия (2) HLR# > 40* Abnormal Retic Pattern** Наследственный или приобретенный сфероцитоз (3) MSCV/MCV < 0. 9 Злокачественные гемопатии Дисмиелопоэз Мегалобластная анемия Другие гемолитические анемии (2) MSCV/MCV > 0. 9 Геморрагии * При серповидноклеточной анемии, HLR # в среднем выше, чем при других типах гемолитической анемии. ** сообщение на Gen. S
Диагностическая схема при анемии Анемии Hb < 13 g/dl Hb < 12 g/dl Нормоцитарная/макроциартная Микроцитарная анемия MCV > 80 fl MCV < 80 fl Ret < 80 000/mm 3 Ret > 100 000/mm 3 IRF & HLR норма/повышен (1) IRF & HLR норма/понижен Периферическая регенеративная Центральная арегенеративная Ret. > 100 000/mm 3 Ret. < 80 000/mm 3 (1) HLR% >1 IRF > 0. 4 IRF < 0. 4 (2) Гемолиз Талассемия (1)According to Watanabe (2)According to results obtained by Fourcade and Jary (3)According to study by Chiron et al. (4)According to unpublished results HLR% < 1 IRF >0. 4 Сидеропеническая анемия/ Анемия воспаления HLR% = 1 (4) Серповидноклеточная анемия (2) HLR# > 40* Abnormal Retic Pattern** Наследственный или приобретенный сфероцитоз (3) MSCV/MCV < 0. 9 Злокачественные гемопатии Дисмиелопоэз Мегалобластная анемия Другие гемолитические анемии (2) MSCV/MCV > 0. 9 Геморрагии * При серповидноклеточной анемии, HLR # в среднем выше, чем при других типах гемолитической анемии. ** сообщение на Gen. S
 Средний объем сферической клетки (MSCV) и клиническое значение MRV и MSCV Влияние реагента для анализа ретикулоцитов на эритроциты Нормальные эритроциты Сфероциты Hematology and Cell Therapy (1999) 41: 113 -116 Chiron M, Cynober T, Mielot F, Tchernia G, Croisille L. Hopital Bicetre, Faculte de medicine, Paris, France
Средний объем сферической клетки (MSCV) и клиническое значение MRV и MSCV Влияние реагента для анализа ретикулоцитов на эритроциты Нормальные эритроциты Сфероциты Hematology and Cell Therapy (1999) 41: 113 -116 Chiron M, Cynober T, Mielot F, Tchernia G, Croisille L. Hopital Bicetre, Faculte de medicine, Paris, France
 Средний объем сферической клетки (MSCV) и клиническое значение MRV и MSCV MRV Средний объем ретикулоцита после ретикулоцита воздействия реагента, обеспечивающего прозрачность клеток (fl) MSCV Средний объем всех красных клеток сферической (включая ретикулоциты) после клетки обработки реагентом, обеспечивающим прозрачность, включая эффект сферической формы (fl) • MSCV выше, чем MCV • Исключение: - наследственный сфероцитоз - MSCV < или = MCV
Средний объем сферической клетки (MSCV) и клиническое значение MRV и MSCV MRV Средний объем ретикулоцита после ретикулоцита воздействия реагента, обеспечивающего прозрачность клеток (fl) MSCV Средний объем всех красных клеток сферической (включая ретикулоциты) после клетки обработки реагентом, обеспечивающим прозрачность, включая эффект сферической формы (fl) • MSCV выше, чем MCV • Исключение: - наследственный сфероцитоз - MSCV < или = MCV
 Средний объем сферической клетки (MSCV) и клиническое значение MRV и MSCV MCV - MSCV = подозрение на наличие наследственного сфероцитоза Gen-S MCV - MSCV Чувствительность Специфичность >0 100% 93. 3% >5 90. 3% 98. 9% >10 71% 99. 6% Для LH 750 примерные значения следующие Чувствительность Специфичность >3 100% 93. 3% >8 90. 3% 98. 9% >13 71% 99. 6% Hematology and Cell Therapy (1999) 41: 113 -116 Chiron M, Cynober T, Mielot F, Tchernia G, Croisille L. Hopital Bicetre, Faculte de medicine, Paris, France
Средний объем сферической клетки (MSCV) и клиническое значение MRV и MSCV MCV - MSCV = подозрение на наличие наследственного сфероцитоза Gen-S MCV - MSCV Чувствительность Специфичность >0 100% 93. 3% >5 90. 3% 98. 9% >10 71% 99. 6% Для LH 750 примерные значения следующие Чувствительность Специфичность >3 100% 93. 3% >8 90. 3% 98. 9% >13 71% 99. 6% Hematology and Cell Therapy (1999) 41: 113 -116 Chiron M, Cynober T, Mielot F, Tchernia G, Croisille L. Hopital Bicetre, Faculte de medicine, Paris, France
 Значения параметров ретикулоцитов для нефрологии MRV 1. 0 < <1. 2 Для здоровых пациентов MCV N= 64 From D’Onofrio. BLOOD 1995, Nº 3. pp 818 -823
Значения параметров ретикулоцитов для нефрологии MRV 1. 0 < <1. 2 Для здоровых пациентов MCV N= 64 From D’Onofrio. BLOOD 1995, Nº 3. pp 818 -823
 Значения параметров ретикулоцитов для нефрологии Анализ дефицитных состояний у пациентов, находящихся на гемодиализе – Vit. B 9/B 12 дефицитная – Железодефицитная 1. 20 < MRV/MCV < 1. 30 < MRV/MCV < 1. 40 – Fe + B 9/B 12 комбинированная MRV/MCV > 1. 4 • Соотношение MRV/MCV увеличивает значимость каждого отдельного параметра и дает информацию об общем статусе пациента. MRV/MCV<1. 35 – отсутствие дефицита железа или фолата MRV/MCV>1. 35 – подозрение на наличие дефицита железа или фолата N=233 With Thanks to Dr. Jurine Regional Dialysis Center, St Etienne, France
Значения параметров ретикулоцитов для нефрологии Анализ дефицитных состояний у пациентов, находящихся на гемодиализе – Vit. B 9/B 12 дефицитная – Железодефицитная 1. 20 < MRV/MCV < 1. 30 < MRV/MCV < 1. 40 – Fe + B 9/B 12 комбинированная MRV/MCV > 1. 4 • Соотношение MRV/MCV увеличивает значимость каждого отдельного параметра и дает информацию об общем статусе пациента. MRV/MCV<1. 35 – отсутствие дефицита железа или фолата MRV/MCV>1. 35 – подозрение на наличие дефицита железа или фолата N=233 With Thanks to Dr. Jurine Regional Dialysis Center, St Etienne, France
 Значения параметров ретикулоцитов для нефрологии Мониторинг лечения эритропоэтином IRF – параметр, позволяющий на самых ранних стадиях оценить ответ на лечение эритропоэтином (IRF>0, 4) Davis B, Ornvold K, Bigelow N. Flow cytometric reticulocyte maturity index: a useful laboratory parameter of erythropoietic activity in anemia. Cytometry. 1995: (22): 22‑ 35. Два этапа высвобождения незрелых ретикулоцитов при введении ЭПО. 1 – немедленно после введения ЭПО 2 – спустя 1 -5 дней после введения – пролиферативный ответ на терапию ЭПО Major A, Bauer C, Breymann C, Huch A, Huch R. rh‑Erythropoietin stimulates immature reticulocyte release in man. British Journal of Haematology. 1994: (87): 605‑ 608.
Значения параметров ретикулоцитов для нефрологии Мониторинг лечения эритропоэтином IRF – параметр, позволяющий на самых ранних стадиях оценить ответ на лечение эритропоэтином (IRF>0, 4) Davis B, Ornvold K, Bigelow N. Flow cytometric reticulocyte maturity index: a useful laboratory parameter of erythropoietic activity in anemia. Cytometry. 1995: (22): 22‑ 35. Два этапа высвобождения незрелых ретикулоцитов при введении ЭПО. 1 – немедленно после введения ЭПО 2 – спустя 1 -5 дней после введения – пролиферативный ответ на терапию ЭПО Major A, Bauer C, Breymann C, Huch A, Huch R. rh‑Erythropoietin stimulates immature reticulocyte release in man. British Journal of Haematology. 1994: (87): 605‑ 608.
 Изменения гематологических параметров после аутотрансплантации стволовых клеток Самый ранний параметр: Day 5: IRF Days after PBSCT Major A, Bauer C, Breymann C, Huch A, Huch R. British Journal of Haematology. 1994: (87): 605‑ 608.
Изменения гематологических параметров после аутотрансплантации стволовых клеток Самый ранний параметр: Day 5: IRF Days after PBSCT Major A, Bauer C, Breymann C, Huch A, Huch R. British Journal of Haematology. 1994: (87): 605‑ 608.
 Значения параметров ретикулоцитов, для мониторинга геморрагических и гемолитических состояний ХИРУРГИЯ/ТЕРАПИЯ • Анализ действия токсических препаратов на костный мозг. • Обнаружение скрытых геморрагий или компенсированного гемолиза. • Контроль эриторопоэтической активности после кровотечения Group 1: регенеративные Group 2 : нерегенеративные 3 Ret# x 10 /mm 3 Day 20 Day 0 Наблюдение двух групп пациентов после операции на сердце Group 1: N=4 Group 2: N=4 With Thanks to Dr. Fourcade University Hospital Argenteuil, France
Значения параметров ретикулоцитов, для мониторинга геморрагических и гемолитических состояний ХИРУРГИЯ/ТЕРАПИЯ • Анализ действия токсических препаратов на костный мозг. • Обнаружение скрытых геморрагий или компенсированного гемолиза. • Контроль эриторопоэтической активности после кровотечения Group 1: регенеративные Group 2 : нерегенеративные 3 Ret# x 10 /mm 3 Day 20 Day 0 Наблюдение двух групп пациентов после операции на сердце Group 1: N=4 Group 2: N=4 With Thanks to Dr. Fourcade University Hospital Argenteuil, France
 Значения параметров ретикулоцитов для классификации анемий В случае нормоцитарной анемии при общем количестве ретикулоцитов 80. 000
Значения параметров ретикулоцитов для классификации анемий В случае нормоцитарной анемии при общем количестве ретикулоцитов 80. 000
 Выводы Анемия – наиболее часто встречающееся отклонение при проведении CBC/diff анализа Классификация на основе MCV полезна Для дальнейшей классификации используются параметры для эритроцитов и ретикулоцитов, получаемые при проведении VCS анализа
Выводы Анемия – наиболее часто встречающееся отклонение при проведении CBC/diff анализа Классификация на основе MCV полезна Для дальнейшей классификации используются параметры для эритроцитов и ретикулоцитов, получаемые при проведении VCS анализа
 Возможности Beckman Coulter в диагностике анемий * В разработке ** Объединенные данные для Roche и Sysmex
Возможности Beckman Coulter в диагностике анемий * В разработке ** Объединенные данные для Roche и Sysmex



